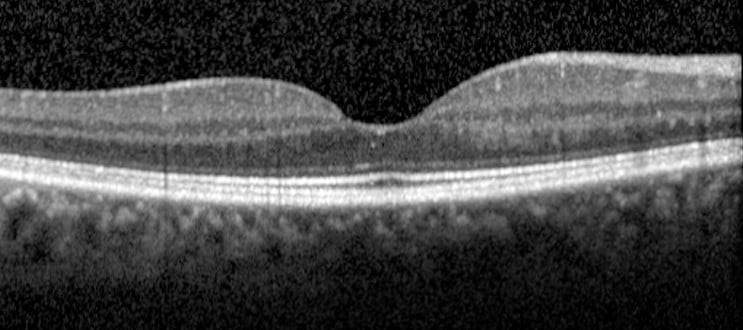

👁Thoái hóa hoàng điểm tuổi già – Đừng để mất thị lực trong im lặng!
Thoái hóa hoàng điểm tuổi già (AMD) là bệnh lý thường gặp ở người trên 50 tuổi, ảnh hưởng trực tiếp đến vùng hoàng điểm – nơi quyết định khả năng nhìn rõ, đọc chữ và nhận diện khuôn mặt. Bệnh tiến triển âm thầm nhưng có thể gây mất thị lực trung tâm nếu không điều trị kịp thời.
🔎Triệu chứng thường gặp:
-
Nhìn mờ, đặc biệt khi đọc sách hoặc nhìn gần
-
Hình ảnh bị méo, đường thẳng thành cong (dấu hiệu điển hình)
-
Khó nhận diện khuôn mặt người đối diện
-
Xuất hiện điểm đen/vùng tối ở trung tâm tầm nhìn
-
Nhìn màu sắc kém rõ ràng
💉Phương pháp điều trị:
-
Theo dõi định kỳ với các trường hợp nhẹ (thể khô)
-
Tiêm thuốc nội nhãn antiVEGF (giúp giảm phù và ngăn tiến triển – thường áp dụng cho thể ướt)
-
Bổ sung vitamin, chất chống oxy hóa hỗ trợ bảo vệ võng mạc
-
Sử dụng các thiết bị hỗ trợ thị lực khi cần
🛡Cách phòng ngừa hiệu quả:
-
Khám mắt định kỳ, đặc biệt từ 50 tuổi trở lên
-
Ăn nhiều rau xanh, cá giàu omega-3, trái cây
-
Không hút thuốc lá 🚫
-
Kiểm soát tốt các bệnh lý như tăng huyết áp, tiểu đường
-
Đeo kính chống tia UV khi ra ngoài
⚠Lưu ý: Phát hiện càng sớm – khả năng giữ được thị lực càng cao!
🏥Hiện nay tại Bệnh viện Mắt Nam Định đã có đầy đủ phương tiện hiện đại để khám chẩn đoán bệnh thoái hóa hoàng điểm tuổi già như máy chụp đáy mắt, máy chụp cắt lớp võng mạc OCT. Đặc biệt, hiện nay Bệnh viện Mắt Nam Định đã được BHYT đồng chi trả trong việc tiêm nội nhãn thuốc antiVEGF để điều trị bệnh thoái hóa hoàng điểm tuổi già thể ướt
👉 Hãy chủ động bảo vệ đôi mắt của bạn và người thân ngay hôm nay.
📩 Inbox cho chúng tôi để được tư vấn và đặt lịch khám sớm!

Hình ảnh chụp đáy mắt bình thường
Hình ảnh OCT đáy mắt bình thường

Hình ảnh chụp đáy mắt AMD thể khô

Hình ảnh OCT đáy mắt AMD thể khô

Hình ảnh chụp đáy mắt AMD thể ướt

Hình ảnh OCT đáy mắt AMD thể ướt